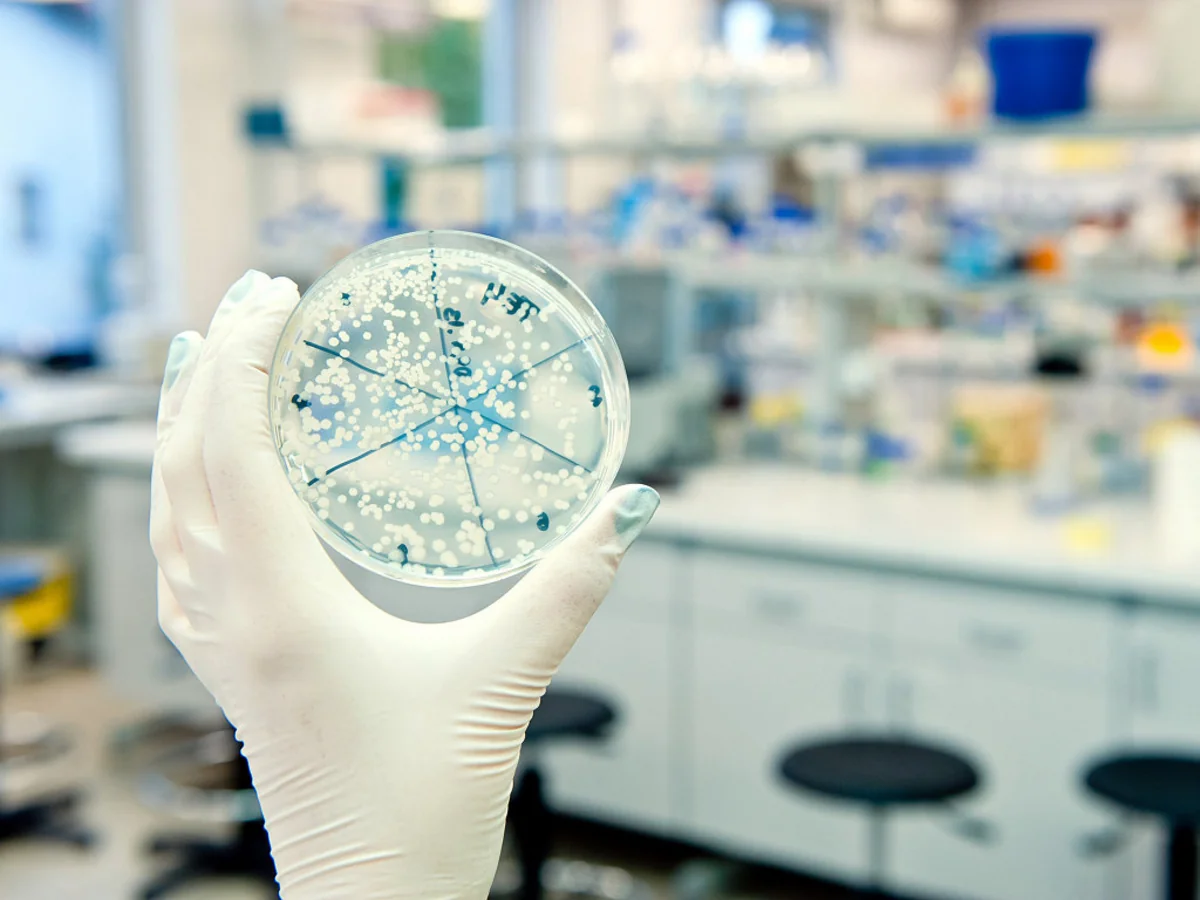
​ÜST: Qvineyada Ebola yoluxucu xəstəliyi yoxdur

ÜST: Qvineyada Ebola yoluxucu xəstəliyi yoxdur
- 29 dekabr, 2015
- 11:53
Bakı. 29 dekabr. REPORT.AZ/ "Qvineyada Ebola yoluxucu xəstəliyi yoxdur".
"Report" BBC-yə istinadən xəbər verir ki, bu haqda Ümumdünya Səhiyyə Təşkilatı (ÜST) məlumat yayıb.
Məlumata görə, Afrikanın qərbində yerləşən bu ölkədə Ebola xəstəliyindən 2,5 min nəfər, qonşu Serra-Leone və Liberiya ölkələrində isə 9 min insan həyatını itirib.
Cari ilin sentyabrında Liberiya, noyabrında isə Serra-Leonedə bu xəstəliyin artıq olmadığı bildirilir.
"Sərhədsiz Həkimlər" Təşkilatı isə qvineyalı həmkarlarını bu yoluxucu xəstəliyin tam məhv edildiyinə əmin olmayanadək sayıqlığı qorumağa çağırıblar.
Bir müddət öncə BMT Qvineyada altı mindən çox uşağın ata və ya anasını, yaxud hər ikisini itirdiyi haqda məlumat yayıb. Bu yoluxucu xəstəlikdən yüzə yaxın tibb işçisi də həyatını itirib.
